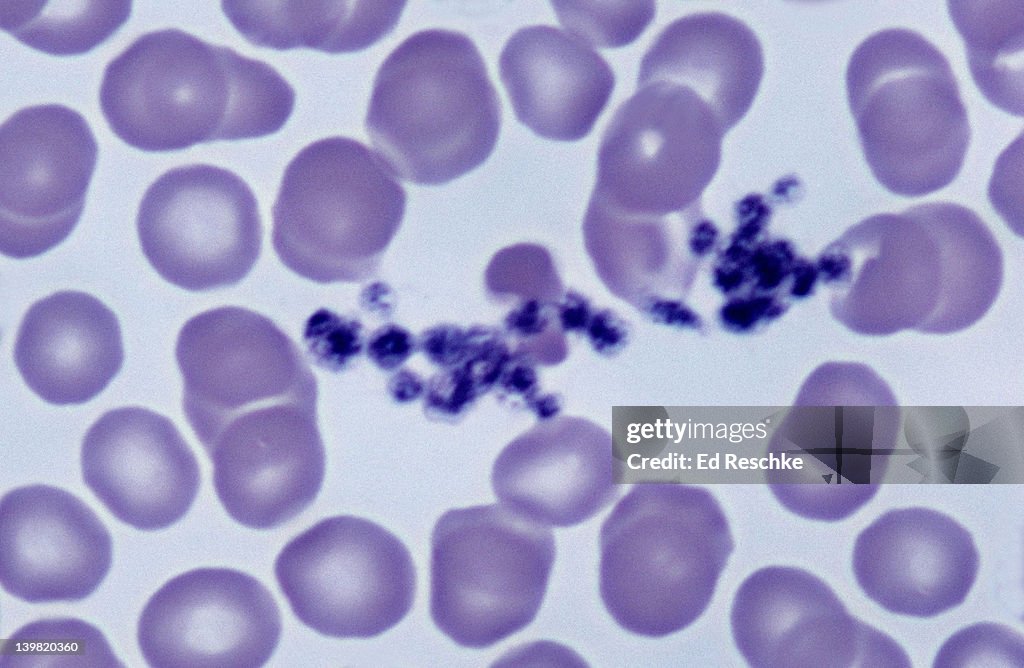
Red blood cells (erythrocytes) & platelets, 500X at 35mm. The platelets are stained purple and many are clumped together. This happens when platelets become sticky and initiate a clot.

Red blood cells (erythrocytes) & platelets, 500X at 35mm. The platelets are stained purple and many are clumped together. This happens when platelets become sticky and initiate a clot. - Fotografia de stock

COMPRAR UMA LICENÇA
Todas as licenças royalty-free incluem direitos globais de utilização, proteção abrangente e preços simples com possibilidade de descontos de volume
385,00 €
EUR
Getty ImagesRed Blood Cells Platelets 500x At 35mm The Platelets Are Stained Purple And Many Are Clumped Together This Happens When Platelets Become Sticky And Initiate A Clot, Foto de stock Faça download de fotografias de stock de Red blood cells (erythrocytes) & platelets, 500X at 35mm. The platelets are stained purple and many are clumped together. This happens when platelets become sticky and initiate a clot. premium e autênticas na Getty Images. Explore fotografias similares de alta resolução no nosso extenso catálogo visual.Product #:139820360
Faça download de fotografias de stock de Red blood cells (erythrocytes) & platelets, 500X at 35mm. The platelets are stained purple and many are clumped together. This happens when platelets become sticky and initiate a clot. premium e autênticas na Getty Images. Explore fotografias similares de alta resolução no nosso extenso catálogo visual.Product #:139820360
Faça download de fotografias de stock de Red blood cells (erythrocytes) & platelets, 500X at 35mm. The platelets are stained purple and many are clumped together. This happens when platelets become sticky and initiate a clot. premium e autênticas na Getty Images. Explore fotografias similares de alta resolução no nosso extenso catálogo visual.Product #:139820360
Faça download de fotografias de stock de Red blood cells (erythrocytes) & platelets, 500X at 35mm. The platelets are stained purple and many are clumped together. This happens when platelets become sticky and initiate a clot. premium e autênticas na Getty Images. Explore fotografias similares de alta resolução no nosso extenso catálogo visual.Product #:139820360385€50€
Getty Images
In stockDETALHES
Crédito:
Creative nº:
139820360
Tipo de licença:
Coleção:
Stone
Tamanho máx.:
4461 x 2911 px (37,77 x 24,65 cm) - 300 dpi - 6 MB
Data do upload:
Inf. sobre autorização:
Não é necessária uma autorização
Categorias: